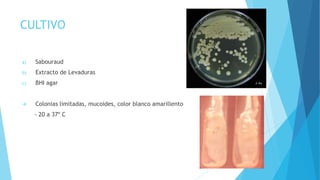
CULTIVO
a) Sabouraud
b) Extracto de Levaduras
c) BHI agar
 Colonias limitadas, mucoides, color blanco amarillento
- 20 a 37º C

Este documento resume las principales micosis pulmonares. Describe la epidemiología, tipos, factores de riesgo y micosis más frecuentes como criptococosis, candidiasis, aspergilosis, histoplasmosis y coccidioidomicosis. Explica en detalle la aspergilosis, su agente causal, cuadro clínico, diagnóstico y tratamiento. También cubre la coccidioidomicosis, su distribución geográfica, manifestaciones clínicas, diagnóstico e imágenes radiológicas característic